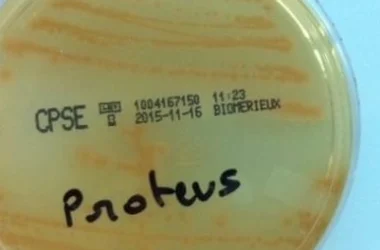

جدول المحتويات
علامات وأعراض صرير الأسنان أثناء النوم
يعتبر صرير الأسنان أثناء النوم مشكلة شائعة تصيب الكثيرين، وقد لا يكون الشخص على دراية بها إلا بعد ظهور بعض العلامات والأعراض. من أبرز هذه العلامات:
- تلف طبقة المينا: يؤدي الضغط المستمر على الأسنان إلى تآكل الطبقة الخارجية الواقية، مما يجعلها أكثر عرضة للتسوس والحساسية.
- انحسار اللثة: قد يتسبب صرير الأسنان في تراجع اللثة، مما يكشف جذور الأسنان ويؤدي إلى حساسيتها.
- صداع متكرر: يعاني الكثير من الأشخاص المصابين بصرير الأسنان من صداع في الصباح، نتيجة للضغط الشديد على عضلات الفك أثناء الليل.
هذه الأعراض قد تكون خفيفة في البداية، ولكن مع مرور الوقت وإذا لم يتم التعامل مع المشكلة، فإنها قد تتفاقم وتؤثر على جودة حياة الشخص.
توقيت حدوث صرير الأسنان
غالباً ما يحدث صرير الأسنان أثناء النوم بشكل لا إرادي، حيث يكون الشخص غير واعي بما يفعله. ومع ذلك، قد يحدث أيضاً أثناء النهار دون أن ينتبه الشخص لذلك.
عند زيارة طبيب الأسنان، قد يلاحظ الطبيب علامات تدل على صرير الأسنان، مثل تآكل الأسنان أو تلف الطبقة الخارجية. هذه العلامات قد تكون مؤشراً على أن الشخص يعاني من هذه المشكلة حتى لو لم يكن يشعر بها.
نتيجة لتآكل الأسنان، قد يصاب الشخص بحساسية الأسنان عند تناول المشروبات الساخنة أو الباردة، وقد يشعر بصداع متكرر.
لذا، يُنصح الأشخاص الذين يعانون من أي من هذه الأعراض بمراجعة طبيب الأسنان في أقرب وقت ممكن لتشخيص المشكلة والبدء في العلاج المناسب.
فيديو توضيحي حول صرير الأسنان أثناء النوم
للمزيد من المعلومات حول صرير الأسنان أثناء النوم، يمكنكم مشاهدة الفيديو التالي الذي يشرح هذه المشكلة بالتفصيل ويوضح أسبابها وأعراضها وكيفية التعامل معها.
[هنا يمكن تضمين رابط أو كود لتضمين الفيديو]
من المهم التذكر بأن الوقاية خير من العلاج، لذا ينصح باتباع النصائح والإرشادات المقدمة من قبل أطباء الأسنان للحفاظ على صحة الأسنان وتجنب مشاكل صرير الأسنان.
الوقاية والعلاج المبكر هما المفتاح للحفاظ على أسنان صحية وابتسامة مشرقة. يجب عدم إهمال أي أعراض قد تشير إلى وجود مشكلة في الأسنان والتوجه إلى الطبيب المختص لتقديم الرعاية اللازمة.
من الجدير بالذكر أن الاهتمام بصحة الفم والأسنان ليس فقط لأسباب جمالية، بل هو جزء أساسي من الصحة العامة. فالأسنان الصحية تساعد على مضغ الطعام بشكل جيد، مما يسهل عملية الهضم ويحسن امتصاص العناصر الغذائية. كما أن صحة الفم الجيدة تقلل من خطر الإصابة بأمراض أخرى مثل أمراض القلب والسكري.
لذلك، يجب الحرص على تنظيف الأسنان بانتظام باستخدام فرشاة الأسنان ومعجون الأسنان المناسبين، بالإضافة إلى استخدام خيط الأسنان لإزالة بقايا الطعام من بين الأسنان. كما ينصح بزيارة طبيب الأسنان بشكل دوري للكشف عن أي مشاكل في الأسنان واللثة وعلاجها في مراحلها الأولى.
في النهاية، نتمنى لكم صحة فم وأسنان جيدة وابتسامة مشرقة تدوم طويلاً.